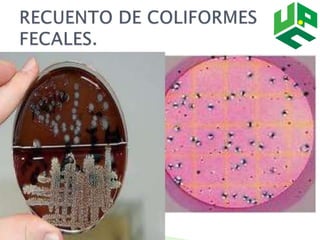

El documento trata sobre la microbiología de la leche. Explica que la leche puede ser afectada por diversas especies microscópicas que causan cambios deseables e indeseables como resultado de su acción. Además, describe las principales características organolépticas y físicas de la leche, los tipos de microorganismos que se encuentran en ella y las fuentes de contaminación microbiana.